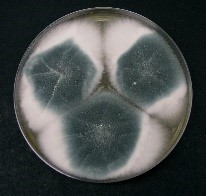
Cultivo de Aspergillus fumigatus de Dr. David Midgley

Aspergillus fumigatus es un hongo filamentoso hialino, saprofito, perteneciente al filo Ascomycota. Se encuentra formado por hifas hialinas tabicadas y puede tener reproducción sexual (con formación de ascosporas en el interior de ascas) y asexual (con formación de conidios).
Las colonias crecen rápidamente a 37ºC, son planas, compactas y tienen un aspecto aterciopelado y un color blanquecino que cambia a verde azulado o verde grisáceo.
Aspergillus es uno de los principales hongos productores de micotoxinas. Las micotoxinas son metabolitos secundarios producidos y secretados por el hongo durante el proceso de degradación de la materia orgánica, como mecanismo de defensa frente a otros microorganismos.
Existen aproximadamente 180 especies de Aspergillus, pero se sabe que poco menos de 40 de ellas causan infecciones en los seres humanos. El Aspergillus fumigatus es la causa más común de las infecciones por Aspergillus en los seres humanos.
Viabilidad, propagación y transmisión
Reservorio
Suelo, vegetales (en descomposición), materiales de construcción, alimentos (granos, cereales) y agua.
Hospedadores
Humanos, bovinos, equinos, aves, cetáceos.
Dosis Infectiva Mínima (DIM)
Se desconoce en la actualidad.
Supervivencia ambiental
Crece en cualquier tipo de sustrato, especialmente en suelos y materiales en descomposición. Es un contaminante habitual de los conductos de climatización-ventilación y polvo de las casas o del ambiente.
Es termotolerante pudiendo vivir entre los 12 y 57ºC.
Formas de resistencia
Las esporas pueden sobrevivir a 70ºC.
Mecanismo de propagación y transmisión
La transmisión se produce principalmente por medio de las esporas o conidios, que se encuentran presentes en el ambiente de trabajo en forma de bioaerosoles y penetran al organismo por vía respiratoria.
También es posible la transmisión por contaminación de heridas o mucosas.
Es responsable de casos de enfermedad nosocomial por contaminación ambiental. No se produce transmisión de persona a persona, ni entre personas y animales.
Vías de entrada
Respiratoria. Mucosas. Percutánea.
Distribución geográfica
Mundial.
Efectos sobre la salud
Grupo de riesgo
2 A
(Ver Anexo II RD 664/1997 )Infección
Patógeno oportunista que causa distintas manifestaciones clínicas: infecciones locales y superficiales como las micosis o aspergilosis cutáneas (otomicosis, onicomicosis, queratitis), el aspergiloma o bola fúngica y la aspergilosis pulmonar crónica que puede desarrollar una cavidad pulmonar.
En individuos con el sistema inmunitario debilitado produce infecciones invasivas, como la aspergilosis invasiva diseminada que cursa de forma grave con neumonía, afectando al pulmón y pudiéndose diseminar a otros órganos.
No está claro cuál es el periodo de incubación de la aspergilosis y probablemente varíe dependiendo de la cantidad de Aspergillus y la respuesta inmunitaria del hospedador.
Efectos alérgicos (Ver Anexo II RD 664/1997 ) / (Ver Allergen )
Asma, rinitis, sinusitis alérgica, alveolitis alérgica extrínseca o neumonitis por hipersensibilidad, enfermedad pulmonar que puede desarrollarse después de la exposición a conidios del hongo, normalmente en trabajos pulvígenos: manipulación de heno mohoso (pulmón del granjero), o fibras de esparto (estipatosis), etc. (7) (8).
Efectos tóxicos (Ver Anexo II RD 664/1997 )
No se han descrito
Efectos cancerígenos (Ver International Agency for Research On Cancer - IARC )
No se han descrito
Efectos en la maternidad
No se han descrito
Enfermedad
| CIE-10 | Nombre | Enfermedad de Declaración Obligatoria |
|---|---|---|
| B44 | Aspergilosis | No |
Actividades laborales con riesgo
Clasificación Nacional de Actividades Económicas (CNAE)
| CNAE 2009 | Descripción |
|---|---|
| A0111 | Cultivo de cereales, distintos de arroz, leguminosas y oleaginosas |
| A0112 | Cultivo de arroz |
| A0113 | Cultivo de hortalizas, raíces y tubérculos |
| A0114 | Cultivo de caña de azúcar |
| A0115 | Cultivo de tabaco |
| A0116 | Cultivo de plantas para fibras textiles |
| A0119 | Otros cultivos no perennes |
| A0121 | Cultivo de la vid |
| A0122 | Cultivo de frutos tropicales y subtropicales |
| A0123 | Cultivo de cítricos |
| A0124 | Cultivo de frutos con hueso y pepitas |
| A0125 | Cultivo de otros árboles y arbustos frutales y frutos secos |
| A0126 | Cultivo de frutos oleaginosos |
| A0127 | Cultivo de plantas para bebidas |
| A0128 | Cultivo de especias, plantas aromáticas, medicinales y farmacéuticas |
| A0129 | Otros cultivos perennes |
| A0130 | Propagación de plantas |
| A0141 | Explotación de ganado bovino para la producción de leche |
| A0142 | Explotación de otro ganado bovino y búfalos |
| A0143 | Explotación de caballos y otros equinos |
| A0144 | Explotación de camellos y otros camélidos |
| A0145 | Explotación de ganado ovino y caprino |
| A0146 | Explotación de ganado porcino |
| A0147 | Avicultura |
| A0148 | Otras explotaciones de ganado |
| A0150 | Producción agrícola combinada con la producción ganadera |
| A0161 | Actividades de apoyo a la agricultura |
| A0162 | Actividades de apoyo a la ganadería |
| A0163 | Actividades de preparación posterior a la cosecha y tratamiento de semillas para reproducción |
| A0170 | Caza, captura de animales y servicios relacionados |
| A0210 | Silvicultura y otras actividades forestales |
| A0220 | Explotación de la madera |
| A0230 | Recolección de productos silvestres, excepto madera |
| A0240 | Servicios de apoyo a la silvicultura |
| B0510 | Extracción de antracita y hulla |
| B0520 | Extracción de lignito |
| B0710 | Extracción de minerales de hierro |
| B0721 | Extracción de minerales de uranio y torio |
| B0729 | Extracción de otros minerales metálicos no férreos |
| B0811 | Extracción de piedra ornamental, piedra caliza, yeso, pizarra y otras piedras |
| B0812 | Extracción de gravas y arenas y extracción de arcilla y caolín |
| B0891 | Extracción de minerales para productos químicos y fertilizantes |
| B0892 | Extracción de turba |
| B0899 | Otras industrias extractivas n.c.o.p. |
| B0990 | Actividades de apoyo a otras industrias extractivas |
| C1011 | Procesado y conservación de carne, excepto volatería |
| C1013 | Elaboración de productos cárnicos y de volatería |
| C1031 | Procesado y conservación de patatas |
| C1032 | Elaboración de zumos de frutas y hortalizas |
| C1039 | Otro procesado y conservación de frutas y hortalizas |
| C1061 | Fabricación de productos de molinería |
| C1081 | Fabricación de azúcar |
| C1082 | Fabricación de cacao, chocolate y productos de confitería |
| C1083 | Elaboración de café, té e infusiones |
| C1084 | Elaboración de especias, salsas y condimentos |
| C1200 | Industria del tabaco |
| C1310 | Preparación e hilado de fibras textiles |
| C1611 | Aserrado y cepillado de la madera |
| C1621 | Fabricación de chapas y tableros de madera |
| C1622 | Fabricación de suelos de madera ensamblados |
| C1623 | Fabricación de otras estructuras de madera y piezas de carpintería y ebanistería para la construcción, excepto las destinadas a construcción industrializada |
| C1624 | Fabricación de envases y embalajes de madera |
| C1628 | Fabricación de otros productos de madera, artículos de corcho, cestería y espartería |
| C1711 | Fabricación de pasta papelera |
| C1712 | Fabricación de papel y cartón |
| E3600 | Captación, depuración y distribución de agua |
| E3700 | Recogida y tratamiento de aguas residuales |
| E3811 | Recogida de residuos no peligrosos |
| E3821 | Valorización de materiales |
| F4101 | Construcción de edificios residenciales |
| F4102 | Construcción de edificios no residenciales |
| F4211 | Construcción de carreteras y autopistas |
| F4212 | Construcción de vías férreas de superficie y subterráneas |
| F4213 | Construcción de puentes y túneles |
| F4221 | Construcción de redes para fluidos |
| F4222 | Construcción de redes eléctricas y de telecomunicaciones |
| F4291 | Obras hidráulicas |
| F4299 | Construcción de otros proyectos de ingeniería civil n.c.o.p. |
| F4311 | Demolición |
| F4312 | Preparación de terrenos |
| F4313 | Perforaciones y sondeos |
| F4322 | Fontanería, instalación de sistemas de calefacción y aire acondicionado |
| F4341 | Construcción de cubiertas |
| G4611 | Actividades de intermediarios del comercio al por mayor de materias primas agrarias, animales vivos, materias primas textiles y productos semielaborados |
| G4613 | Actividades de intermediarios del comercio al por mayor de la madera y materiales de construcción |
| G4617 | Actividades de intermediarios del comercio al por mayor de productos alimenticios, bebidas y tabaco |
| G4621 | Comercio al por mayor de cereales, tabaco en rama, simientes y alimentos para animales |
| G4622 | Comercio al por mayor de flores y plantas |
| G4623 | Comercio al por mayor de animales vivos |
| G4631 | Comercio al por mayor de frutas y hortalizas |
| G4635 | Comercio al por mayor de productos del tabaco |
| G4636 | Comercio al por mayor de azúcar, chocolate y confitería |
| G4637 | Comercio al por mayor de café, té, cacao y especias |
| G4639 | Comercio al por mayor, no especializado, de productos alimenticios, bebidas y tabaco |
| N7210 | Investigación y desarrollo experimental en ciencias naturales y técnicas |
| N7500 | Actividades veterinarias |
| O8123 | Otras actividades de limpieza |
| O8130 | Actividades de jardinería |
| R8699 | Otras actividades sanitarias n.c.o.p. |
| S9112 | Actividades de archivos |
| S9122 | Actividades de sitios históricos y monumentos |
| S9141 | Actividades de los jardines botánicos y los parques zoológicos |
| T9630 | Pompas fúnebres y actividades relacionadas |
Clasificación Nacional de Ocupaciones (CNO)
| CNO 2011 | Descripción |
|---|---|
| 2130 | Veterinarios |
| 2210 | Profesores de universidades y otra enseñanza superior (excepto formación profesional) |
| 2421 | Biólogos, botánicos, zoólogos y afines |
| 2422 | Ingenieros agrónomos |
| 2423 | Ingenieros de montes |
| 2424 | Ingenieros técnicos agrícolas |
| 2425 | Ingenieros técnicos forestales y del medio natural |
| 2426 | Profesionales de la protección ambiental |
| 2427 | Enólogos |
| 2432 | Ingenieros en construcción y obra civil |
| 2436 | Ingenieros de minas, metalúrgicos y afines |
| 2454 | Ingenieros geógrafos y cartógrafos |
| 2462 | Ingenieros técnicos de obras públicas |
| 2466 | Ingenieros técnicos de minas, metalúrgicos y afines |
| 2483 | Ingenieros técnicos en topografía |
| 2821 | Sociólogos, geógrafos, antropólogos, arqueólogos y afines |
| 2911 | Archivistas y conservadores de museos |
| 3122 | Técnicos en construcción |
| 3128 | Técnicos en metalurgia y minas |
| 3132 | Técnicos en instalaciones de tratamiento de residuos, de aguas y otros operadores en plantas similares |
| 3141 | Técnicos en ciencias biológicas (excepto en áreas sanitarias) |
| 3142 | Técnicos agropecuarios |
| 3143 | Técnicos forestales y del medio natural |
| 3314 | Técnicos en laboratorio de diagnóstico clínico |
| 3327 | Ayudantes de veterinaria |
| 4121 | Empleados de control de abastecimientos e inventario |
| 4122 | Empleados de oficina de servicios de apoyo a la producción |
| 4123 | Empleados de logística y transporte de pasajeros y mercancías |
| 4210 | Empleados de bibliotecas y archivos |
| 4221 | Empleados de servicios de correos (excepto empleados de mostrador) |
| 5892 | Empleados de pompas fúnebres y embalsamadores |
| 5932 | Bomberos forestales |
| 5992 | Bañistas-socorristas |
| 5993 | Agentes forestales y medioambientales |
| 6110 | Trabajadores cualificados en actividades agrícolas (excepto en huertas, invernaderos, viveros y jardines) |
| 6120 | Trabajadores cualificados en huertas, invernaderos, viveros y jardines |
| 6201 | Trabajadores cualificados en actividades ganaderas de vacuno |
| 6202 | Trabajadores cualificados en actividades ganaderas de ovino y caprino |
| 6203 | Trabajadores cualificados en actividades ganaderas de porcino |
| 6205 | Trabajadores cualificados en la avicultura y la cunicultura |
| 6209 | Trabajadores cualificados en actividades ganaderas no clasificados bajo otros epígrafes |
| 6300 | Trabajadores cualificados en actividades agropecuarias mixtas |
| 6410 | Trabajadores cualificados en actividades forestales y del medio natural |
| 6430 | Trabajadores cualificados en actividades cinegéticas |
| 7131 | Carpinteros (excepto ebanistas) |
| 7250 | Mecánicos-instaladores de refrigeración y climatización |
| 7291 | Montadores de cubiertas |
| 7295 | Personal de limpieza de fachadas de edificios y chimeneas |
| 7617 | Artesanos en madera y materiales similares; cesteros, bruceros y trabajadores afines |
| 7618 | Artesanos en tejidos, cueros y materiales similares, preparadores de fibra y tejedores con telares artesanos o de tejidos de punto y afines |
| 7708 | Preparadores y elaboradores del tabaco y sus productos |
| 7811 | Trabajadores del tratamiento de la madera |
| 7812 | Ajustadores y operadores de máquinas para trabajar la madera |
| 7820 | Ebanistas y trabajadores afines |
| 7833 | Cortadores de tejidos, cuero, piel y otros materiales |
| 7836 | Curtidores y preparadores de pieles |
| 7894 | Fumigadores y otros controladores de plagas y malas hierbas |
| 8111 | Mineros y otros operadores en instalaciones mineras |
| 8112 | Operadores en instalaciones para la preparación de minerales y rocas |
| 8113 | Sondistas y trabajadores afines |
| 8143 | Operadores de máquinas para fabricar productos de papel y cartón |
| 8144 | Operadores de serrerías, de máquinas de fabricación de tableros y de instalaciones afines para el tratamiento de la madera y el corcho |
| 8145 | Operadores en instalaciones para la preparación de pasta de papel y fabricación de papel |
| 8151 | Operadores de máquinas para preparar fibras, hilar y devanar |
| 8155 | Operadores de máquinas para tratar pieles y cuero |
| 8160 | Operadores de máquinas para elaborar productos alimenticios, bebidas y tabaco |
| 8331 | Operadores de maquinaria de movimientos de tierras y equipos similares |
| 8332 | Operadores de grúas, montacargas y de maquinaria similar de movimiento de materiales |
| 9210 | Personal de limpieza de oficinas, hoteles y otros establecimientos similares |
| 9229 | Otro personal de limpieza |
| 9441 | Recogedores de residuos |
| 9442 | Clasificadores de desechos, operarios de punto limpio y recogedores de chatarra |
| 9443 | Barrenderos y afines |
| 9511 | Peones agrícolas (excepto en huertas, invernaderos, viveros y jardines) |
| 9512 | Peones agrícolas en huertas, invernaderos, viveros y jardines |
| 9520 | Peones ganaderos |
| 9530 | Peones agropecuarios |
| 9543 | Peones forestales y de la caza |
| 9601 | Peones de obras públicas |
| 9602 | Peones de la construcción de edificios |
| 9603 | Peones de la minería, canteras y otras industrias extractivas |
| 9700 | Peones de las industrias manufactureras |
| 9811 | Peones del transporte de mercancías y descargadores |
Prevención y control
Desinfectantes
Glutaraldehído al 0.5%, hipoclorito sódico, cloruro de benzalconio, clorohexidina (3) y sulfato de cobre.
Inactivación física
La irradiación con microondas a 800 vatios de 90 segundos a 2 minutos es eficaz para inactivar los conidios.
El tratamiento con calor a 60ºC durante 45 minutos reduce la concentración inicial de conidios.
Antimicrobianos
Voriconazol (algunas cepas son resistentes), itraconazol, anfotericina, posaconazol, isavuconazol, caspofungina y micafungina (7).
Vacunación
No disponible
Medidas preventivas generales
Disponer de ventilación adecuada en los lugares de trabajo, evitar la humedad relativa alta y condensaciones, además de implantar un programa periódico de limpieza y mantenimiento de locales, instalaciones y equipos, especialmente en el sistema de climatización-ventilación del edificio.
Evitar procesos pulvígenos o que generen bioaerosoles, si no se pueden evitar, cerramiento o aislamiento de dichos procesos o disponer de un sistema de extracción localizada.
Almacenar los productos de origen animal o vegetal: cuero, tejidos, residuos orgánicos, paja, cereales, madera, café, tabaco, bagazo, etc. en condiciones relativamente secas y en recintos bien ventilados para prevenir el enmohecimiento.
Adoptar unas correctas medidas de higiene, no comer, ni beber en el lugar de trabajo, lavado de manos, evitar la exposición de heridas abiertas, utilizar ropa de trabajo y equipos de protección individual.
Precauciones en centros sanitarios
En hospitales o centros sanitarios, adoptar las Precauciones Estándar y precauciones por contacto y aéreas en caso de paciente con infección masiva de los tejidos blandos o con abundante drenaje e irrigaciones repetidas (6) (13).
EPI
Protección de las manos: guantes en la manipulación de materiales contaminados (frutos secos, estiércol, tierra, etc.).
Protección respiratoria: mascarillas autofiltrantes por lo menos FFP2, o máscaras con filtros P2 en tareas que puedan generar bioaerosoles o polvo.
Protección ocular: gafas de protección de montura universal en caso de riesgo de contacto accidental mano/guante contaminado-ojo, o pantalla de protección facial (símbolo de marcado en montura: 3) en tareas que impliquen la generación de polvo, bioaerosoles o salpicaduras o gafa de protección de montura integral con hermeticidad frente a partículas (símbolo de marcado en montura: 4), en caso de riesgo de exposición a polvo.
Seguridad en laboratorio
Nivel de contención: 2
El principal riesgo es la inhalación de bioaerosoles contaminados.
Las muestras más peligrosas son especímenes biológicos como: esputo, tejidos procedentes de biopsias, aspirados traqueales o procedentes de broncoscopias y sangre. También muestras procedentes de suelo o productos contaminados como: cereales, frutos secos, heno, etc.
Se requieren las prácticas y la contención de un nivel 2 de bioseguridad con el empleo de cabina de seguridad biológica en aquellas operaciones que impliquen la generación de aerosoles, proyecciones o salpicaduras y el uso de guantes impermeables en el caso de contacto con muestras contaminadas. El uso de agujas, jeringas y otros objetos punzantes debe limitarse estrictamente. Se deben considerar precauciones adicionales con trabajos que involucren animales o actividades a gran escala.
Bibliografía
- Alcalá, L., Muñoz, P. Peláez, T., & Bouza, E. Aspergillus y aspergilosis. Sociedad Española de Enfermedades Infecciosas y Microbiología Clínica (SEIMC).
- Delgado, A., Sandoval, R., Choez, K., Rodríguez, I. K., García, C., & Lopez, B. (2018). Micotoxicosis por toxinas tremorgénicas: un problema que puede presentarse en su establo. Actualidad ganadera.
- Mattei, A. S., Madrid, I. M., Santin, R., Schuch, L. F., & Meireles, M. C. (2013). In vitro activity of disinfectants against Aspergillus spp. Brazilian journal of microbiology, 44(2), 481-484. DOI: 10.1590/S1517-83822013000200024.
- Nienimen, S. M., Kärki, R., Auriola, S., Toivola, M., Laatsch, H., Laatikainen, R., Hyvärinen, A., & Von Wright, A. (2002). Isolation and identification of Aspergillus fumigatus mycotoxins on growth medium and some building materials. Applied and environmental microbiology, 68(10), 4871-4875. DOI: 10.1128/AEM.68.10.4871-4875.2002.
- Pontón, J., Moragues, M. D., Gené, J., Guarro, J., & Quindós, G. (2002). Hongos y actinomicetos alergénicos. Revista Iberoamericana de Micología.
- Centers for Disease Control and Prevention (CDC). (2019). Guideline for isolation precautions: preventing transmission of infectious agents in healthcare settings. CDC: Infection control.
- Centers for Disease Control and Prevention (CDC). (2021). Aspergilosis. CDC: Fungal diseases.
- Comisión de Salud Pública del Consejo Interterritorial del Sistema Nacional de Salud. Ministerio de Sanidad y Consumo. (2000). Protocolo de vigilancia sanitaria específica para los/as trabajadores/as expuestos a Neumonitis por Hipersensibilidad o Alveolitis Alérgica Extrínseca.
- Institut National de Recherche et de Sécurité (INRS). (2023). Aspergillus fumigatus. BAse d'OBservation des Agents Biologiques (BAOBAB).
- Institut National de Recherche et de Sécurité (INRS). Documents pour le médicin du travail, nº 119 (TC 128) y nº 121 (TC 131).
- Instituto Nacional de Seguridad y Salud en el Trabajo (INSST). Notas Técnicas de Prevención (NTP): 299, 313, 335, 351, 488, 539, 597, 700, 771, 781, 802, 805, 806 y 822.
- Public Health Agency of Canada. (2010). Aspergillus spp. Pathogen Safety Data Sheets.
- Servicio Riojano de Salud. (2008). Precauciones de aislamiento en centros sanitarios.